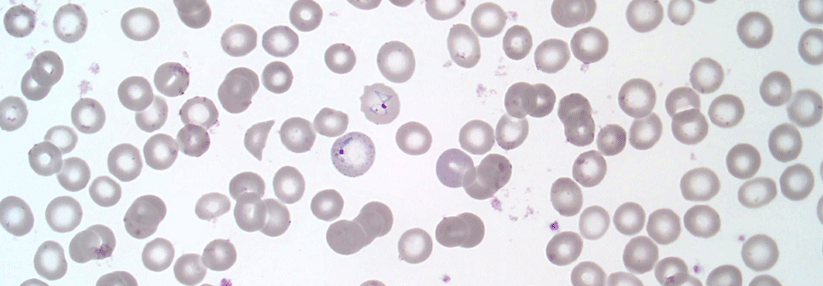

Artemisininresistente Erreger Malariatherapie in Gefahr
 Der Malariaerreger Plasmodium falciparum entwickelt in einigen Regionen Resistenzen gegenüber Artemisinin.
© jarun011 – stock.adobe.com
Der Malariaerreger Plasmodium falciparum entwickelt in einigen Regionen Resistenzen gegenüber Artemisinin.
© jarun011 – stock.adobe.com
Forscher beobachten eine wachsende Teilresistenz des Malariaerregers Plasmodium falciparum gegenüber Artemisinin. Nach Südostasien ist davon auch Afrika zunehmend betroffen. Dort treten 95 % aller Malariafälle auf.
Eine Kombinationstherapie mit Artemisinin ist seit Beginn des Jahrhunderts bei unkompliziertem Krankheitsverlauf Standard. Wie eine seit 2016 jährlich durchgeführte Untersuchung in Uganda zeigt, steigt der Anteil an Markern für resistente oder potenziell resistente Mutationen kontinuierlich. Im Jahr 2022 lag dieser in 11 von 16 Provinzen bereits bei über 20 %, in einigen Regionen sogar deutlich höher. Die fünf identifizierten Mutationen entwickelten sich eigenständig und stehen mit denen in Südostasien nicht in Verbindung. Der Trend ist seit 2016 besonders in Gebieten zu verzeichnen, in denen wirksame Maßnahmen zur Malariakontrolle ausgesetzt wurden bzw. nur eingeschränkt verfügbar waren.
Quelle: Conrad MD et al. N Engl J Med 2023; 389: 722-732; DOI: 10.1056/NEJMoa2211803